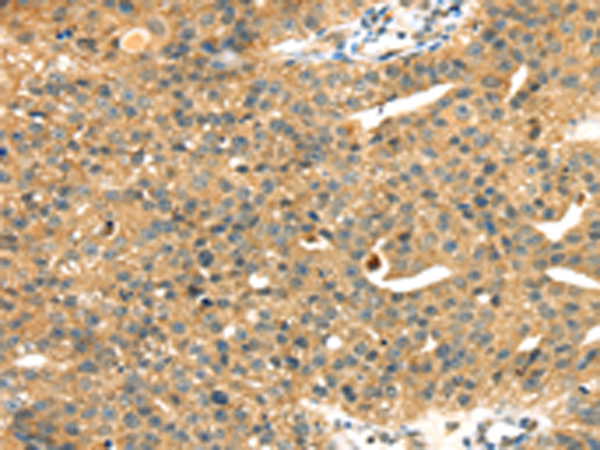
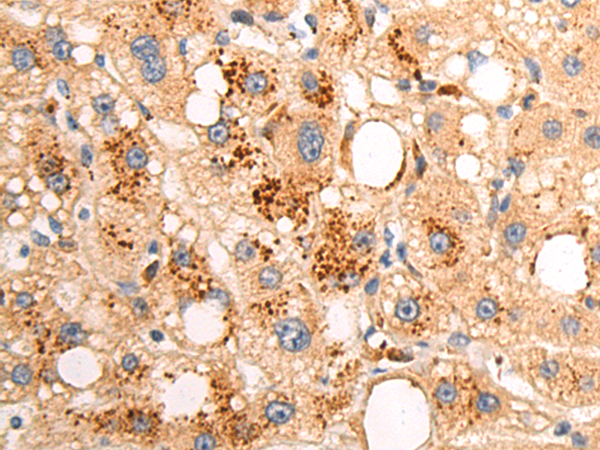

-
分类: 科研抗体货号: P08725别名: FIP1; RAGA; FIP-1应用: WB,IHC反应种属: Human, Mouse, Rat
-
分类: 科研抗体货号: P08724别名: RSK; HU-1; RSK1; MAPKAPK1A应用: WB,IHC反应种属: Human, Mouse, Rat
-
分类: 科研抗体货号: P08723别名: S3应用: WB,IHC反应种属: Human, Mouse, Rat
-
分类: 科研抗体货号: P08743别名: COX2; COX-2; PHS-2; PGG/HS; PGHS-2; hCox-2; GRIPGHS应用: WB,IHC反应种属: Human, Mouse, Rat
-
分类: 科研抗体货号: P08722别名: P2; LP2; RPP2; D11S2243E应用: IHC反应种属: Human, Mouse, Rat
-
分类: 科研抗体货号: P08742别名:应用: IHC反应种属: Human, Mouse, Rat
-
分类: 科研抗体货号: P08721别名: P1; LP1; RPP1应用: WB,IHC反应种属: Human, Mouse, Rat
-
分类: 科研抗体货号: P08741别名: ERK3; ERK6; SAPK3; PRKM12; SAPK-3; P38GAMMA应用: WB,IHC反应种属: Human, Mouse, Rat
-
分类: 科研抗体货号: P08720别名: L15; EC45; DBA12; RPL10; RPLY10; RPYL10应用: IHC反应种属: Human, Mouse, Rat
-
分类: 科研抗体货号: P08740别名:应用: IHC反应种属: Human

鄂公网安备42018502007531号
鄂公网安备42018502007531号

